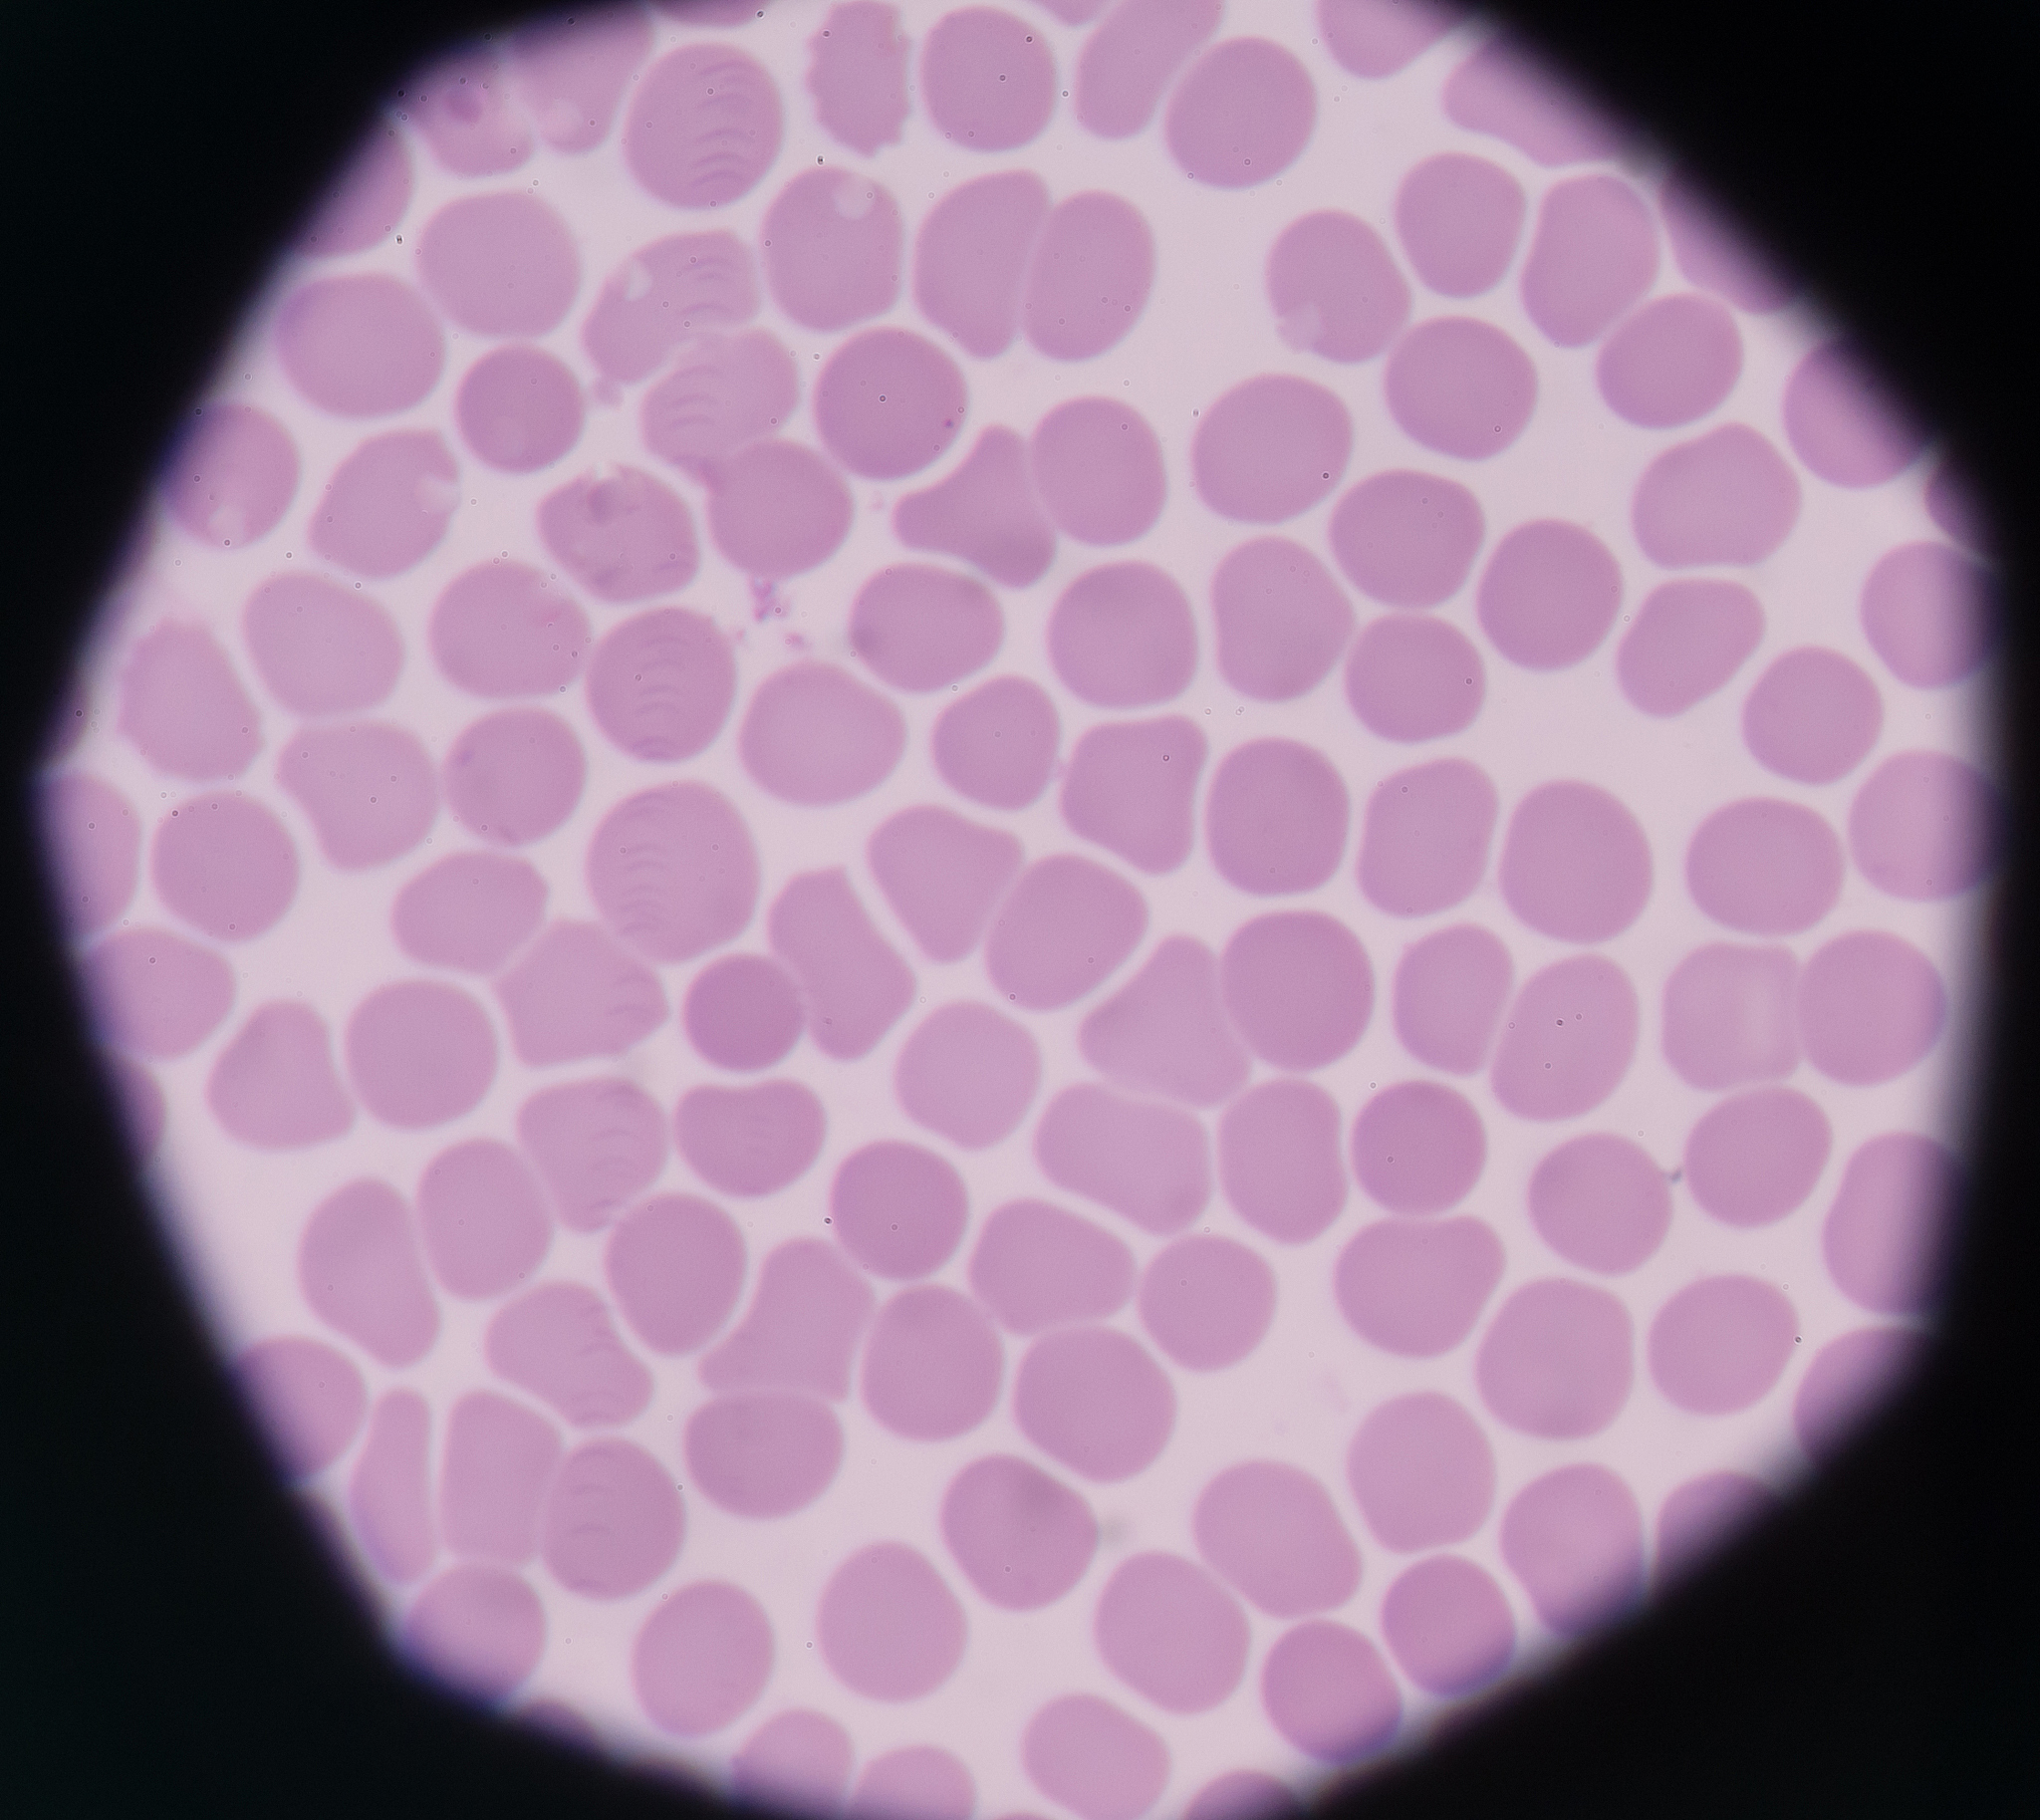
血小板在血涂片中难以观察的原因

血小板在血涂片中难以观察的原因
血小板在血涂片中不容易看到的原因是因为血小板在血液中数量较少,且其形态特殊,很容易和其他细胞混淆。此外,血小板在血液中的寿命较短,容易在制备血涂片的过程中破裂或聚集在一起,使其更难以观察。因此,需要使用特殊染色方法或显微镜技术才能更清晰地观察和计数血小板。

原文地址: https://www.cveoy.top/t/topic/okz3 著作权归作者所有。请勿转载和采集!
安全问答是一个知识全球问答,包含丰富的问答知识
血小板在血涂片中不容易看到的原因是因为血小板在血液中数量较少,且其形态特殊,很容易和其他细胞混淆。此外,血小板在血液中的寿命较短,容易在制备血涂片的过程中破裂或聚集在一起,使其更难以观察。因此,需要使用特殊染色方法或显微镜技术才能更清晰地观察和计数血小板。
原文地址: https://www.cveoy.top/t/topic/okz3 著作权归作者所有。请勿转载和采集!